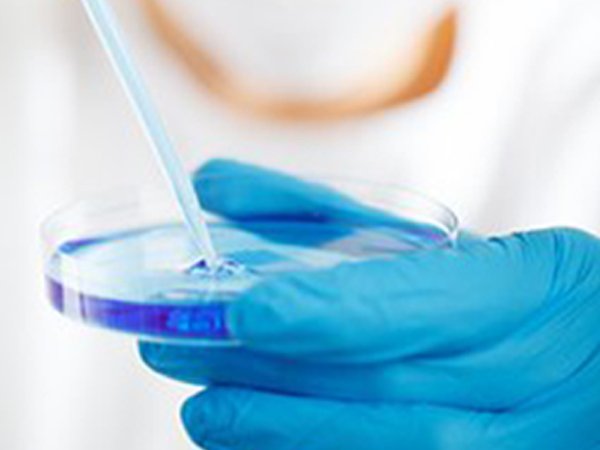
Pseudogout

Latest Updates
-
వడగాల్పుల వేళ గర్భిణులు, పీసీఓఎస్ బాధితులు ఈ జాగ్రత్తలు తీసుకోకపోతే ప్రమాదమే! -
టాక్సిక్ మ్యారేజెస్ అంటే ఏంటి? అనుపమ సీరియల్ చూశాక మహిళలు ఎందుకు మారుతున్నారు? -
బండి మీద దొరికే క్రిస్పీ సమోసా..ఇక ఇంట్లోనే చాలా ఈజీగా! -
మ్యాట్రిమోనీలో ఇస్రో శాస్త్రవేత్తనని నమ్మించి.. మహిళను రూ. 26 లక్షలకు ముంచేసిన కేటుగాడు! -
ఉత్తర భారత్లో మండుతున్న ఎండలు.. వడదెబ్బ నుంచి ప్రాణాలు కాపాడుకోవాలంటే ఈ చిట్కాలు తప్పనిసరి! -
బరువు తగ్గుతున్నా పొట్ట తగ్గట్లేదా? అయితే మీరు చేస్తున్న పెద్ద తప్పు ఇదే! -
ఒక్క చుక్క నూనె లేకుండా స్ట్రీట్ స్టైల్ రగడా చాట్.. ఇలా చేస్తే టేస్ట్ అదుర్స్! -
JEE అడ్వాన్స్డ్ 2026 రిజిస్ట్రేషన్ మొదలైంది.. ఇంజనీరింగ్ సీటు మీ సొంతం కావాలంటే ఈ జాగ్రత్తలు తప్పనిసరి! -
రొటీన్ ఇడ్లీ, దోశలు బోర్ కొట్టాయా? అయితే ఈ కమ్మటి వెజిటబుల్ ఎగ్ సేమియా ట్రై చేయండి! -
మీ కిడ్నీలు ఆరోగ్యంగా ఉండాలంటే..ఈ పొరపాట్లు అస్సలు చేయకండి!
సూడోగౌట్: కారణాలు, లక్షణాలు, రోగ నిర్ధారణ మరియు చికిత్స
సూడోగౌట్ అనేది ఒక రకమైన ఆర్థరైటిస్ సంబంధిత వ్యాధిగా చెప్పబడుతుంది. ఇది శరీరంలోని ఒకటి లేదా అంతకంటే ఎక్కువ జాయింట్లలో (కీళ్ళ భాగం) ఆకస్మిక మరియు బాధాకరమైన వాపుకు కారణమవుతుంది. ఈ విధమైన నొప్పి తరచుగా, మరియు రోజులు లేదా వారాలపాటు కొనసాగుతూ ఉంటుంది. సర్వసాధారణంగా ప్రభావితమయ్యే భాగంగా మోకాళ్ళు ఉంటాయి. ఈ అనారోగ్యాన్ని కాల్షియం పైరోఫాస్ఫేట్ డీపొజిషన్ వ్యాధి లేదా CPPD అని కూడా వ్యవహరించడం జరుగుతుంది.
ఈ సూడో గౌట్ లక్షణాలు కూడా సాధారణ గౌట్ తరహాలోనే ఉంటాయి. గౌట్ మరియు సూడోగౌట్ రెండూ స్ఫటిక నిక్షేపాలు పేర్కొనడం కారణంగా ఏర్పడే తీవ్రపరిస్థితులుగా చెప్పబడుతాయి. (స్వల్ప తేడాలతో). అంతేకాకుండా వయసుతోపాటుగా ఈ పరిస్థితి తలెత్తే ప్రమాదం పెరుగుతూ ఉంటుంది. వాపును తగ్గించడానికి, మరియు నొప్పి నుండి ఉపశమనం పొందడానికి సహాయపడే చికిత్సలు అనేకం అందుబాటులో ఉన్నాయి. ఈ పరిస్థితిని గురించిన మరిన్ని వివరాలకోసం వ్యాసంలో ముందుకు సాగండి.

అసలు సూడోగౌట్ అంటే ఏమిటి?
ఈ స్థితిని కీళ్ళ వాపు (ఆర్థరైటిస్)రకంగా గుర్తించడం జరుగుతుంది. కీళ్లు మరియు కీళ్ల చుట్టూ కాల్షియం పైరోఫాస్ఫేట్ అని పిలవబడే స్ఫటికాల నిక్షేపాలు పేరుకుని పోవడం మూలంగా ఈ వాపు తలెత్తుతుంది. గౌట్ అనే పరిస్థితికి సారూప్య లక్షణాలు అనేకం ఉన్నప్పటికీ, ఇన్ఫ్లమేషన్ సమస్యకు కారణమయ్యే క్రిస్టల్స్ ను పరిగణనలోనికి తీసుకున్నప్పుడు ఈ పరిస్థితి భిన్నంగా కనిపిస్తుంది (గౌట్ విషయంలో మోనోసోడియం యూరేట్ క్రిస్టల్స్ పేరుకోవడం జరుగుతుంది). ఈ భిన్న పరిస్థితులలో ఏర్పడే స్ఫటికాలు భిన్నసారూప్యతను కలిగి ఉంటాయి. ఒక మైక్రోస్కోప్ కింద జాయింట్ ఫ్లూయిడ్ చూసినప్పుడు వీటిని తేలికగా గమనించవచ్చునని చెప్పబడుతుంది. ఈ పరీక్ష జాయింట్ ఇన్ఫ్లమేషన్ సమస్యకు గల కారణాన్ని ఖచ్చితంగా గుర్తించడానికి వైద్యునికి సహాయపడుతుంది.
కొన్ని సందర్భాలలో, సూడోగౌట్ అనేది అప్పుడప్పుడు గౌట్ (ఒకే ఉమ్మడి ద్రవంలో కనిపించే రెండు రకాల స్ఫటికాలవలె) సమస్యలో ఉన్నట్లుగానే స్పటిక నిక్షేపాలను కలిగి ఉన్నట్లు కనిపిస్తుంది. సూడోగౌట్ కారణంగా ఏర్పడే జాయింట్లలో బాధాకరమైన వాపు కనిపిస్తుంది. సరైన సమయంలో చికిత్సను అందివ్వకపోతే, కీళ్ల నష్టానికి కూడా దారితీస్తుంది. కొన్ని అరుదైన సందర్భాలలో, ఈ పరిస్థితి భుజాలు, పిరుదులు, మోచేతులు, కాలి వేళ్లు మరియు చీలమండలను సైతం ప్రభావితం చేసేలా కనిపిస్తుంది.
సూడోగౌట్ సమస్యకు కారణాలు :
చాలా కేసులలో స్ఫటికాలు ఏర్పడటానికి గల సరైన కారణం ఇప్పటికీ అంతుచిక్కడంలేదు. ఏదేమైనప్పటికీ, వయసు పెరగడంతోపాటుగా ఈ స్పటికాల నిక్షేపాలు కూడా అసాధారణంగా పెరుగుతాయని చెప్పబడుతుంది. కాల్షియం పైరోఫాస్ఫేట్ డీహైడ్రేట్ క్రిస్టల్స్ యొక్క నిక్షేపాలు ఒక కీలు యొక్క మృదులాస్థిలో పేరుకొంటూ ఉన్నప్పుడు, అది సూడోగౌట్ సమస్యకు దారితీయగలదని వైద్యులు చెప్తున్నారు. ఈ స్ఫటికాలు కీళ్ల నొప్పి, వాపులను కలిగించే ద్రవంలోకి విడుదలవుతుంటాయి.
ఈ పరిస్థితి డీజనరేటివ్ ఆర్థరైటిస్ సమస్యతో కూడా సంబంధం కలిగి ఉంటుంది. ఈ సమస్య తలెత్తిన సమయంలో, అనేక ఇతరత్రా సమస్యలు కూడా డీహైడ్రేషన్ కారణంగా సంభవించవచ్చు. కొన్ని సందర్భాలలో, సూడోగౌట్, కాల్షియం జీవక్రియల మీద ఉండే హార్మోనుల ప్రభావాల కారణంగా తలెత్తే హైపర్ పారాథైరాయిడిజం సమస్య కారణంగా సంభవిస్తుందని కనుగొన్నారు.
సూడోగౌట్ సమస్యకు గల ప్రదాన కారణాలు :
ఈ క్రింది కారకాలు మీ సూడోగౌట్ యొక్క ప్రమాదాన్ని పెంచగలవు :
జెనెటిక్స్ :
కొన్ని కుటు౦బాల్లో, సూడోగౌట్ సమస్య అభివృద్ధి చె౦దడానికి వంశపారంపర్యత కారణమని కనుగొన్నారు. ఇటువంటి వారు అతి పిన్న వయస్సులోనే సూడోగౌట్ సమస్యను కలిగి ఉన్నట్లుగా చెప్పబడుతుంది.

జాయింట్ ట్రౌమా :
తీవ్రమైన గాయం లేదా శస్త్రచికిత్స (కీళ్లదగ్గర) అనేది సూడోగౌట్ అభివృద్ధికి దారితీస్తుంది.
వయసు :
సూడోగౌట్ సమస్య వయసు ప్రభావం కారణంగా కూడా తలెత్తవచ్చు.
ఖనిజాల అసమతుల్యతలు :
అధిక స్థాయిలలో ఇనుము లేదా కాల్షియం, లేదా అతి తక్కువ స్థాయిలలో మెగ్నీషియం ఉన్న వ్యక్తులకు సూడోగౌట్ సోకే ప్రమాదం చాలా ఎక్కువగా ఉంటుంది.
ఇతర వైద్య కారణాలు :
హైపర్ థైరాయిడిజం : థైరాయిడ్ గ్రంధి, లేదా అతిచురుకుగా ఉండే పారా థైరాయిడ్ గ్రంధి కూడా సూడోగౌట్ సమస్యకు దారితీస్తుంది.
సూడోగౌట్ లక్షణాలు :
ఈ పరిస్థితి యొక్క అత్యంత సాధారణ లక్షణాలు ఈ క్రింది విధంగా ఉన్నాయి :
• తీవ్రమైన మరియు ఆకస్మిక కీళ్లనొప్పి.
• కీళ్ళ దగ్గర వాపు, ఇది తాకినప్పుడు నొప్పిగా ఉంటుంది.
ప్రభావితమైన కీలు చుట్టూ ఎరుపు లేదా ఊదారంగు చర్మం ఉండడం.
• ప్రభావితమైన కీళ్ళ చుట్టూ మృదువుగా మారడం.
• కొన్ని సందర్భాల్లో, సూడోగౌట్ మూలంగా దీర్ఘకాలిక వాపు కూడా ఏర్పడవచ్చు.
కొన్నిసార్లు ఈ కీళ్ల నొప్పులు రుమటాయిడ్ ఆర్దరైటిస్ సమస్యను అనుకరించి ఉంటుంది. వాపు తీవ్రంగా ఉన్నప్పుడు, అది కీళ్ళలో చలనం మరియు పనితీరు కోల్పోవడానికి దారితీస్తుంది.
సూడోగౌట్ వ్యాధి నిర్ధారణ :
సూడోగౌట్ ఉనికిని నిర్ధారించడానికి ల్యాబ్ మరియు ఇమేజింగ్ పరీక్షలు అవసరంగా ఉంటాయి.
ల్యాబ్ టెస్టులు:
థైరాయిడ్ మరియు పారాథైరాయిడ్ గ్రంధి సమస్యలకు చెక్ పెట్టడానికి రక్త పరీక్షలను నిర్వహించవచ్చు. ఈ పరీక్షలలో ఖనిజాల అసమతుల్యతలను కూడా పరీక్షించడం జరుగుతుంది. స్ఫటికాల ఉనికిని పరీక్షించడం కొరకు, సూదిని ఉపయోగించి ప్రభావిత కీళ్ళ ప్రాంతం నుండి జాయింట్ ఫ్లూయిడ్ నమూనాను తీసుకోవడం జరుగుతుంది.
ఇమేజింగ్ పరీక్షలు :
కీళ్లలోని మృదులాస్థిలో జాయింట్ డ్యామేజ్, మరియు క్రిస్టల్ నిక్షేపాలను గుర్తించడానికి ప్రభావిత కీలు భాగంలో ఎక్స్-రే తీయడం జరుగుతుంది.
సూడోగౌట్ సమస్యకు చికిత్స :
సూడోగౌట్ సమస్యకు ప్రత్యేకించిన చికిత్స అంటూ లేనప్పటికీ, కొన్ని ఇతర సమస్యల చికిత్సల కలయిక ద్వారా నొప్పి నుండి ఉపశమనానికి తోడ్పడవచ్చు. క్రమంగా కీళ్ళ పనితీరును మెరుగుపరచడానికి కూడా ఈ చికిత్సలు సహాయపడగలవు.

మీ వైద్యుడి ద్వారా దిగువ పేర్కొన్న ఔషధాలను సిఫారసు చేయవచ్చు :
మీ వైద్యుడు దిగువ పేర్కొన్న ఔషధాలను సిఫారసు చేయవచ్చు :
నాన్ స్టెరాఇడల్ యాంటీ ఇన్ఫ్లమేటరీ మందులు :
వీటిలో సాధారణంగా నాప్రోక్సేన్ మరియు ఇండోమెథాసిన్ ప్రధానంగా ఉంటాయి. అయితే, ఈ ఔషదాలు కడుపులో రక్తస్రావం మరియు పెద్దవారిలో మూత్రపిండాల పనితీరు తగ్గడం వంటి కారణాలతో ముడిపడి ఉంటుంది.
కోల్చిసిన్ :
ఇది గౌట్ వ్యాధికి వినియోగించే మందు. అయితే, ఈ మాత్ర యొక్క తక్కువ మోతాదులు, సూడోగౌట్ లక్షణాల నుండి ఉపశమనానికి అద్భుతంగా పనిచేస్తాయని చెప్పబడుతుంది.

కార్టికోస్టెరాయిడ్స్ :
ప్రెడినిసోన్ వంటి మాత్రలు వాపును తగ్గించి, బాధాకరమైన నొప్పిని హరించడంలో సహాయపడగలవు. అయితే దీర్ఘకాలిక కార్టికోస్టెరాయిడ్ల వాడకం మూలంగా కంటి శుక్లాలు ఏర్పడడం, బరువు పెరగటం, మధుమేహం వంటి దీర్ఘకాలిక సమస్యలకు కారణమవడం, ఎముకలు బలహీనపడడం మొదలైనవి తలెత్తవచ్చు.
పునరావృత సూడోగౌట్ సమస్య యొక్క దీర్ఘకాలిక నివారణ కోసంగా, కోల్చిసిన్, మరియు సరైన హైడ్రేషన్ స్థాయిలను (శరీరానికి సరైన మోతాదులలో నీటిని అందివ్వడం) నిర్వహించడం ద్వారా నివారణా చర్యలను తీసుకోవచ్చు.
జాయింట్ డ్రైనేజీ అనేది సూడోగౌట్ సమస్యతో బాధపడుతున్న కొందరు రోగులకు ఉపయోగించే మరొక చికిత్సా పధ్ధతిగా ఉంటుంది. ప్రభావిత కీలు భాగం నుండి, ఒత్తిడి మరియు నొప్పి నుంచి ఉపశమనం పొందేక్రమంలో భాగంగా ఈ ప్రక్రియను ఉపయోగించడం జరుగుతుంది. జాయింట్ ఫ్లూయిడ్లో కొంతభాగాన్ని తొలగించడం కొరకు ఒక సూదిని జొప్పించడం జరుగుతుంది. ఇది ప్రభావిత ప్రాంతంలో కీళ్ళ నుండి కొన్ని స్ఫటికాలను తొలగించడంలో ఉత్తమంగా సహాయపడుతుందని చెప్పబడుతుంది. ఈ ప్రక్రియ, వాపు తగ్గించడం చేసే కార్టికో స్టెరాయిడ్ ఇంజెక్షన్ తో ముగుస్తుంది.
సూడోగౌట్ సమస్యతో జీవించడం :
ఈ పరిస్థితికి ఎటువంటి చికిత్సలు లేవు కనుక, మీ లక్షణాలను తగ్గించే మార్గాలను కనుగొనడమే ఉత్తమ నిర్వహణా పధ్ధతిగా చెప్పబడుతుంది. మీకు అత్యుత్తమంగా సరిపోయే చికిత్సా విధానాలను కనుగొనేందుకు మీ వైద్యునితో చర్చించండి. మీ ఇంట్లోనే, వాపును తగ్గించుకోవడానికి కోల్డ్ ప్యాక్స్ ఉపయోగించడం కూడా చేయవచ్చు. అదేవిధంగా ప్రభావిత కీళ్ళ భాగానికి ఒత్తిడి కలుగకుండా నిర్వహిస్తున్నారని ధృవీకరించుకోండి. కనీసం 2 రోజులపాటు, ఆ కీళ్ళపై భారంపడకుండా చూసుకోవాలని గుర్తుంచుకోండి.
నోట్ : శరీరంలో నీటినిల్వలను నిర్వహించడం ద్వారా, అనేక దీర్ఘకాలిక సమస్యలకు ప్రారంభంలోనే చెక్ పెట్టవచ్చు. కనీసం 2 గంటలకు ఒకసారి అర లీటర్ మంచినీళ్ళు తీసుకోవలసినదిగా సూచించడమైనది.
ఈ వ్యాసం మీకు నచ్చినట్లయితే మీ ప్రియమైన వారితో పంచుకోండి. ఇటువంటి అనేక ఆసక్తికర ఆరోగ్య, మాతృత్వ, శిశు సంక్షేమ, జీవన శైలి, ఆహార, లైంగిక, వ్యాయామ, ఆద్యాత్మిక, జ్యోతిష్య, హస్త సాముద్రిక, తదితర సంబంధిత విషయాల కోసం బోల్డ్స్కై పేజీని తరచూ సందర్శించండి. ఈ వ్యాసంపై మీ అభిప్రాయాలను, వ్యాఖ్యలను క్రింద వ్యాఖ్యల విభాగంలో తెలియజేయండి.
Disclaimer: ఈ ఆర్టికల్ లో అందించిన సమాచారం సాధారణ సమాచారం,విద్యా ప్రయోజనాల కోసం మాత్రమే. ఇది వృత్తిపరమైన వైద్య సలహా, రోగ నిర్ధారణ లేదా ట్రీట్మెంట్ కు ప్రత్యామ్నాయంగా ఉద్దేశించబడలేదు. వైద్య పరిస్థితికి సంబంధించి మీకు ఏవైనా ప్రశ్నలు ఉంటే మీ డాక్టర్ లేదా సంబంధిత నిపుణుల సలహా తీసుకోండి.



Click it and Unblock the Notifications